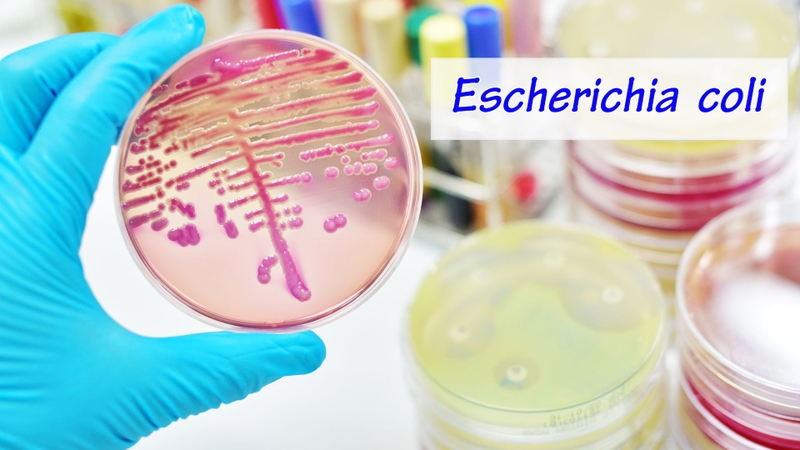
Trong công nghiệp, Spermidine chủ yếu được sản xuất bằng công nghệ lên men vi sinh, sử dụng các chủng vi khuẩn hoặc nấm men đã được tối ưu hóa gen

- Tìm hiểu chung
- Liều dùng & cách dùng
- Ứng dụng
- Lưu ý
- Tìm hiểu chung
- Liều dùng & cách dùng
- Ứng dụng
- Lưu ý
Spermidine là gì? Công dụng và cách dùng
31/01/2026
Mặc định
Lớn hơn
Spermidine là một polyamine tự nhiên có trong cơ thể người và nhiều loại thực phẩm như đậu nành, lúa mì, nấm và phô mai ủ. Hoạt chất này nổi bật nhờ khả năng kích hoạt quá trình tự thực bào (autophagy), giúp tế bào dọn dẹp chất thải và làm chậm lão hóa ở mức sinh học. Spermidine đang được nghiên cứu rộng rãi trong lĩnh vực kéo dài tuổi thọ và phòng ngừa bệnh tim mạch. Ở liều bổ sung thông thường, Spermidine được xem là an toàn và không có tính gây nghiện hay độc tính đặc hiệu.
- Tìm hiểu chung
- Liều dùng & cách dùng
- Ứng dụng
- Lưu ý
- Tìm hiểu chung
- Liều dùng & cách dùng
- Ứng dụng
- Lưu ý
Tìm hiểu chung
Spermidine là gì?
Spermidine là một polyamine tự nhiên có mặt sẵn trong cơ thể người và được hấp thu thêm từ thực phẩm như đậu nành, ngũ cốc nguyên hạt, nấm và phô mai ủ. Ở cấp độ sinh học, Spermidine không phải là vitamin hay hormone, mà là một phân tử điều hòa nội bào tham gia trực tiếp vào việc ổn định DNA, RNA, protein và các phân tử năng lượng như ATP. Nhờ đặc tính mang điện tích dương, Spermidine có khả năng gắn vào các cấu trúc mang điện tích âm trong tế bào, từ đó duy trì cấu trúc nhiễm sắc thể, ribosome và hệ thống dịch mã.
Điểm đặc biệt nhất của Spermidine nằm ở khả năng kích hoạt tự thực bào (autophagy) - cơ chế tự làm sạch và tái chế của tế bào, giúp loại bỏ protein lỗi, bào quan hư hỏng và các cấu trúc bị oxy hóa. Spermidine thực hiện điều này thông qua ức chế enzyme EP300 và làm giảm acetyl-CoA, tạo điều kiện cho các protein autophagy (Atg) và yếu tố dịch mã eIF5A hoạt động hiệu quả. Nhờ đó, hệ thống lysosome và tái chế nội bào được tăng cường, giúp tế bào duy trì trạng thái sạch và ổn định.
Song song với autophagy, Spermidine còn tác động mạnh lên ty thể, trung tâm tạo năng lượng của tế bào. Thông qua trục SIRT1/PGC-1α, Spermidine thúc đẩy sinh tổng hợp ty thể và cải thiện hiệu suất tạo ATP, giúp tế bào duy trì năng lượng và khả năng chống chịu với stress sinh học. Đồng thời, Spermidine làm giảm stress oxy hóa do ROS, nhờ đó bảo vệ DNA, hạn chế đột biến và duy trì tính toàn vẹn của bộ gen.
Một nhánh quan trọng khác của Spermidine là chống viêm sinh học. Hoạt chất này ức chế inflammasome và trục NF-κB, làm giảm các cytokine gây viêm như IL-1β và IL-18 - những phân tử trung tâm của hiện tượng viêm mạn tính liên quan đến lão hóa (inflammaging). Việc điều hòa thêm tín hiệu insulin/IGF giúp Spermidine can thiệp vào các con đường sinh học quyết định tuổi thọ tế bào.
Spermidine được xem là một trong những phân tử nội sinh quan trọng nhất trong nghiên cứu lão hóa khỏe mạnh và phòng ngừa suy thoái tế bào. Ở liều dinh dưỡng và bổ sung thông thường, Spermidine được đánh giá là an toàn, không gây nghiện và không có độc tính đặc hiệu, chủ yếu đóng vai trò như một yếu tố hỗ trợ sinh học hơn là một thuốc điều trị.

Điều chế sản xuất Spermidine
Trong tự nhiên, Spermidine được tạo ra trong tế bào sống thông qua con đường chuyển hóa từ các acid amin, chủ yếu là ornithine và methionine. Quá trình này bắt đầu khi ornithine được chuyển thành putrescine, sau đó nhận thêm nhóm amin từ decarboxylated S-adenosyl-methionine (dcSAM) để hình thành Spermidine. Đây là con đường sinh học chuẩn tồn tại ở người, thực vật, vi khuẩn và nấm men.
Trong sản xuất công nghiệp, Spermidine hiện nay chủ yếu được tạo ra bằng lên men vi sinh. Các chủng vi khuẩn hoặc nấm men được chọn lọc (thường là Escherichia coli hoặc Saccharomyces cerevisiae đã tối ưu hóa gen) sẽ được nuôi trong môi trường giàu carbon và nitơ. Thông qua kiểm soát pH, oxy, nhiệt độ và nguồn tiền chất, tế bào vi sinh sẽ tổng hợp và tích lũy Spermidine trong môi trường nuôi cấy. Sau đó, Spermidine được thu hồi bằng các bước lọc, chiết, tinh chế bằng sắc ký và kết tinh để đạt độ tinh khiết dùng cho thực phẩm chức năng hoặc nghiên cứu sinh học.
Ngoài lên men sinh học, Spermidine cũng có thể được tạo ra bằng tổng hợp hóa học, nhưng phương pháp này phức tạp, tốn kém và dễ tạo tạp chất. Vì vậy, trong thực tế thương mại, lên men sinh học được xem là con đường ưu tiên vì tạo ra Spermidine có cấu trúc giống hệt dạng tự nhiên, độ tinh khiết cao và phù hợp cho sử dụng trong lĩnh vực dinh dưỡng và y sinh.
Cơ chế hoạt động
Spermidine hoạt động như một chất điều hòa sinh học đa tầng, giúp tế bào duy trì trạng thái chức năng trẻ và ổn định. Trục trung tâm của cơ chế này là kích hoạt tự thực bào (autophagy) thông qua ức chế enzyme EP300 và làm giảm acetyl-CoA, từ đó tạo điều kiện cho các protein Atg và yếu tố dịch mã eIF5A hoạt động hiệu quả trong hệ thống dọn dẹp và tái chế nội bào. Đồng thời, Spermidine còn tăng cường hoạt hóa TFEB và chức năng lysosome, giúp loại bỏ protein lỗi và cấu trúc hư hỏng, duy trì cân bằng protein trong tế bào.
Ở mức năng lượng và stress oxy hóa, Spermidine kích hoạt trục SIRT1/PGC-1α, thúc đẩy sinh tổng hợp ty thể và tạo ATP, đồng thời làm giảm tín hiệu stress do ROS, qua đó bảo vệ DNA và ổn định bộ gen. Hoạt chất này cũng ức chế inflammasome và NF-κB, làm giảm các cytokine gây viêm như IL-1β và IL-18, góp phần hạn chế viêm mạn tính liên quan đến lão hóa. Việc điều hòa tín hiệu insulin/IGF bổ sung thêm một lớp kiểm soát sinh học đối với tuổi thọ tế bào.
Công dụng
Spermidine là một polyamine sinh học có vai trò quan trọng trong việc duy trì sự sống và tính ổn định của tế bào. Công dụng nổi bật nhất của Spermidine là kích hoạt quá trình tự thực bào, giúp tế bào phân hủy và tái chế các protein bị lỗi, bào quan hư hỏng và cấu trúc nội bào suy thoái, từ đó hạn chế stress oxy hóa và viêm mạn tính. Nhờ cơ chế này, Spermidine góp phần bảo vệ tế bào và làm chậm các quá trình lão hóa ở mức độ tế bào.
Bên cạnh đó, Spermidine có khả năng gắn với DNA, RNA và phospholipid màng, giúp ổn định cấu trúc vật chất di truyền và màng tế bào, đồng thời hỗ trợ các quá trình sao chép, phiên mã và phân chia tế bào diễn ra chính xác. Hoạt chất này cũng tham gia điều hòa chuyển hóa và phản ứng thích nghi với stress, giúp tế bào duy trì chức năng sinh lý trong điều kiện bất lợi.
Tóm lại, Spermidine không hoạt động như một chất kích thích tức thời, mà đóng vai trò như một bộ điều hòa sinh học nền tảng, giúp tế bào tự làm sạch, tự sửa chữa và duy trì trạng thái ổn định lâu dài, từ đó góp phần bảo toàn chức năng của mô và cơ quan theo thời gian.

Liều dùng & cách dùng
Spermidine có thể được đưa vào cơ thể theo hai con đường chính: Từ thực phẩm tự nhiên và dạng bổ sung.
Trong chế độ ăn, Spermidine có nhiều trong đậu nành, natto, đậu lăng, đậu Hà Lan, ngũ cốc nguyên hạt, nấm, phô mai ủ và mầm lúa mì. Khi được hấp thu qua đường tiêu hóa, Spermidine đi vào tuần hoàn và phân bố đến các mô, nơi nó tham gia điều hòa các quá trình như tự thực bào và chuyển hóa tế bào.
Ở dạng bổ sung, Spermidine thường được dùng đường uống, dưới dạng viên hoặc bột, với liều phổ biến trong các nghiên cứu dinh dưỡng khoảng 1 - 6 mg mỗi ngày. Mức này nhằm mô phỏng lượng Spermidine mà những người có chế độ ăn giàu polyamine tự nhiên thường đạt được, chứ không phải liều điều trị.
Spermidine có thể dùng lúc đói hoặc no, nhưng hấp thu thường ổn định hơn khi uống cùng bữa ăn. Việc sử dụng thường mang tính dài hạn, vì Spermidine tác động thông qua các cơ chế sinh học nền tảng như tự thực bào, chức năng ty thể và kiểm soát viêm, chứ không tạo hiệu ứng nhanh tức thì.
Ở liều bổ sung thông thường, Spermidine được đánh giá là an toàn, không gây nghiện và không có độc tính đặc hiệu. Tuy nhiên, việc dùng liều cao kéo dài không được khuyến khích, vì polyamine ở nồng độ quá cao có thể ảnh hưởng đến cân bằng tăng sinh và chức năng tế bào.

Ứng dụng
Trong y học và dược phẩm
Spermidine không phải là thuốc điều trị, mà là một phân tử sinh học nền tảng được quan tâm trong nghiên cứu y sinh. Thông qua tác động lên tự thực bào, chức năng ty thể, viêm và ổn định bộ gen, Spermidine đang được khảo sát trong các hướng liên quan đến lão hóa khỏe mạnh, bệnh tim mạch, thoái hóa thần kinh và rối loạn chuyển hóa. Trong dược học, nó được xem là một chất điều hòa sinh học tiềm năng, có thể hỗ trợ chức năng tế bào và tăng khả năng thích nghi của mô trước các yếu tố gây stress bệnh lý.
Trong công nghệ sinh học và nuôi cấy tế bào
Spermidine được sử dụng như một chất hỗ trợ sinh lý tế bào. Nhiều nghiên cứu cho thấy việc bổ sung Spermidine có thể cải thiện tự thực bào, giảm stress oxy hóa và giúp tế bào duy trì chức năng ổn định hơn trong điều kiện nuôi cấy. Nhờ đó, nó được quan tâm trong các hệ thống nuôi tế bào gốc, tế bào miễn dịch và tế bào sản xuất protein tái tổ hợp, nơi độ bền và tuổi thọ tế bào ảnh hưởng trực tiếp đến hiệu suất sản xuất sinh học.
Trong nông nghiệp công nghệ cao
Spermidine là một polyamine nội sinh có vai trò quan trọng trong khả năng thích nghi của thực vật với stress môi trường. Việc tăng hàm lượng Spermidine hoặc kích hoạt con đường sinh tổng hợp của nó trong cây trồng đã được chứng minh có thể cải thiện khả năng chịu hạn, mặn, nhiệt độ cao và giảm tổn thương do oxy hóa. Vì vậy, Spermidine đang được nghiên cứu như một công cụ sinh học tiềm năng trong canh tác bền vững và nâng cao sức chống chịu của cây trồng.
Trong mỹ phẩm
Trong lĩnh vực chăm sóc da, Spermidine được nghiên cứu như một hoạt chất hỗ trợ duy trì chức năng tế bào da. Nhờ khả năng kích hoạt tự thực bào và hỗ trợ bảo vệ DNA, Spermidine giúp tế bào loại bỏ protein hư hỏng, giảm stress oxy hóa và duy trì hoạt động của ty thể. Những cơ chế này góp phần giúp da phục hồi tốt hơn và hạn chế các thay đổi sinh học liên quan đến lão hóa da theo thời gian. Vì vậy, một số dòng mỹ phẩm chống lão hóa đã đưa Spermidine vào công thức như một thành phần hướng tới cải thiện sức khỏe tế bào da.

Lưu ý
Các lưu ý khi sử dụng Spermidine:
- Spermidine không phải là thuốc điều trị, mà là một yếu tố sinh học hỗ trợ, nên không dùng để thay thế thuốc kê đơn trong các bệnh tim mạch, thần kinh hay rối loạn chuyển hóa.
- Nên dùng ở liều sinh lý, thường trong khoảng 1–6 mg/ngày, nhằm mô phỏng lượng Spermidine tự nhiên từ chế độ ăn giàu polyamine.
- Không nên dùng liều cao kéo dài, vì polyamine ở nồng độ quá lớn có thể kích thích tăng sinh tế bào quá mức và làm mất cân bằng nội môi.
- Người đang mắc ung thư, tiền ung thư hoặc bệnh lý tăng sinh tế bào nên hỏi ý kiến bác sĩ trước khi dùng, do Spermidine có thể ảnh hưởng đến chu trình tế bào.
- Phụ nữ mang thai, cho con bú và trẻ em không nên tự ý dùng dạng bổ sung Spermidine do chưa có đủ dữ liệu an toàn dài hạn.
- Spermidine hấp thu tốt hơn khi dùng cùng bữa ăn, đặc biệt là bữa ăn có protein và chất béo.
- Nên ưu tiên nguồn Spermidine từ thực phẩm tự nhiên hoặc sản phẩm bổ sung có tiêu chuẩn chất lượng rõ ràng.
- Không nên kết hợp bừa bãi với các chất kích hoạt autophagy mạnh khác (như rapamycin, berberine liều cao, fasting kéo dài) vì có thể gây stress chuyển hóa.
- Highly efficient biosynthesis of spermidine from L-homoserine and putrescine using an engineered Escherichia coli with NADPH self-sufficient system: https://pubmed.ncbi.nlm.nih.gov/35931895/
- A comprehensive review of spermidine: Safety, health effects, absorption and metabolism, food materials evaluation, physical and chemical processing, and bioprocessing: https://pubmed.ncbi.nlm.nih.gov/35478379/
- Overexpression of Spermidine Synthase Enhances Tolerance to Multiple Environmental Stresses and Up-Regulates the Expression of Various Stress-Regulated Genes in Transgenic Arabidopsis thaliana: https://academic.oup.com/pcp/article-abstract/45/6/712/1857377?
- Spermidine rescues the deregulated autophagic response to oxidative stress of osteoarthritic chondrocytes: https://pubmed.ncbi.nlm.nih.gov/32305648/
- Spermidine-Rich Foods and Their Anti-Aging Benefits: https://www.news-medical.net/health/Spermidine-Rich-Foods-and-Their-Anti-Aging-Benefits.aspx#what-is-spermidine
- spermidine: https://lifespan.io/topic/spermidine-benefits-side-effects/
:format(webp)/Option_1_2_2d9677e5fd.png)
:format(webp)/Option_1_1_2a84e0cd00.png)
